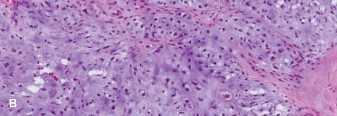
Illustration 7 for Mastering Orthopedics Oncology: Chondrosarcoma Cases

A 61-year-old female with several months of deep pain in the right shoulder is
referred to you by her primary care physician. She presents to your office with the radiographs and an MRI is obtained (Fig. 8–17A–C).


Figure 8–17 A–B

Figure 8–17 C
Which of the following is true regarding the lesion shown inFigure 8–17A–C. 1. Needle biopsy is not as accurate in determining the grade as in other tumors
2. Lesions within the pelvis should be treated with neoadjuvant chemotherapy prior to resection
3. Lesions of the extremities should be treated with wide resection or amputation, regardless of their grade, because of high instance of skip lesions
4. When this lesion arises in the hand, it is especially concerning for metastasis
Discussion
The correct answer is (A). Chondrosarcoma is a malignant cartilage-producing tumor. Three grades exist, in addition to a dedifferentiated form, and histopathologic examination of these lesions is not as reliable predictor of grade as in other lesions. For this reason, evaluation of the imaging is critical in determining the appropriate management. Location is important to the diagnosis of these lesions; for example, lesions in the hand are most commonly benign enchondromas, while those in the scapula are more commonly malignant. These tumors have little or no sensitivity to chemotherapy and radiation; therefore surgical resection is the primary treatment. For grade 1 lesions of the extremities, which are locally aggressive but have limited, if any, potential to metastasize, intralesional curettage and bone grafting is an accepted treatment with low recurrence rate. Pelvis lesions of any grade generally have a poorer prognosis, so wide resection is preferred in
the pelvis even for grade 1 chondrosarcoma. An open surgical biopsy is performed. Biopsy slide is shown inFigure 8–18A and B. Treatment for this patient should consist of: A. Preoperative radiation and wide resection with reconstruction
B. Postoperative radiation and wide resection with reconstruction
C. Preoperative chemotherapy and amputation
D. Wide resection and reconstruction


Figure 8–18 A

Figure 8–18 B
Discussion
The correct answer is (D). This is a chondrosarcoma. Figure 8–18A shows tumor surrounding all bony trabeculae, and the higher power view seen in Figure 8–18B demonstrates a very cellular tumor with pleiomorphism. Chondrosarcoma is treated
with wide resection and if applicable, reconstruction. Preoperative radiation and/or chemotherapy have no usefulness in treatment of chondrosarcoma. Postoperative x-ray is shown inFigure 8–
- Which of the following complications is seen more commonly in allograft osteoarticular reconstruction than after this type of reconstruction? A. Aseptic loosening

Figure 8–19
Discussion
The correct answer is (B). Allograft reconstructions of the proximal humerus have a higher rate of postoperative fracture than endoprosthetic reconstructions. However, aseptic loosening, abductor dysfunction leading to instability, and proximal migration are all postoperative problems that can be seen with endoprosthetic reconstructions of the humerus. Objectives: Did you learn...?
To recognize chondrosarcoma imaging? To recognize chondrosarcoma histology? Treatment of chondrosarcoma?
Reconstructive options and pros and cons of various long bone reconstructions
for malignant tumors?